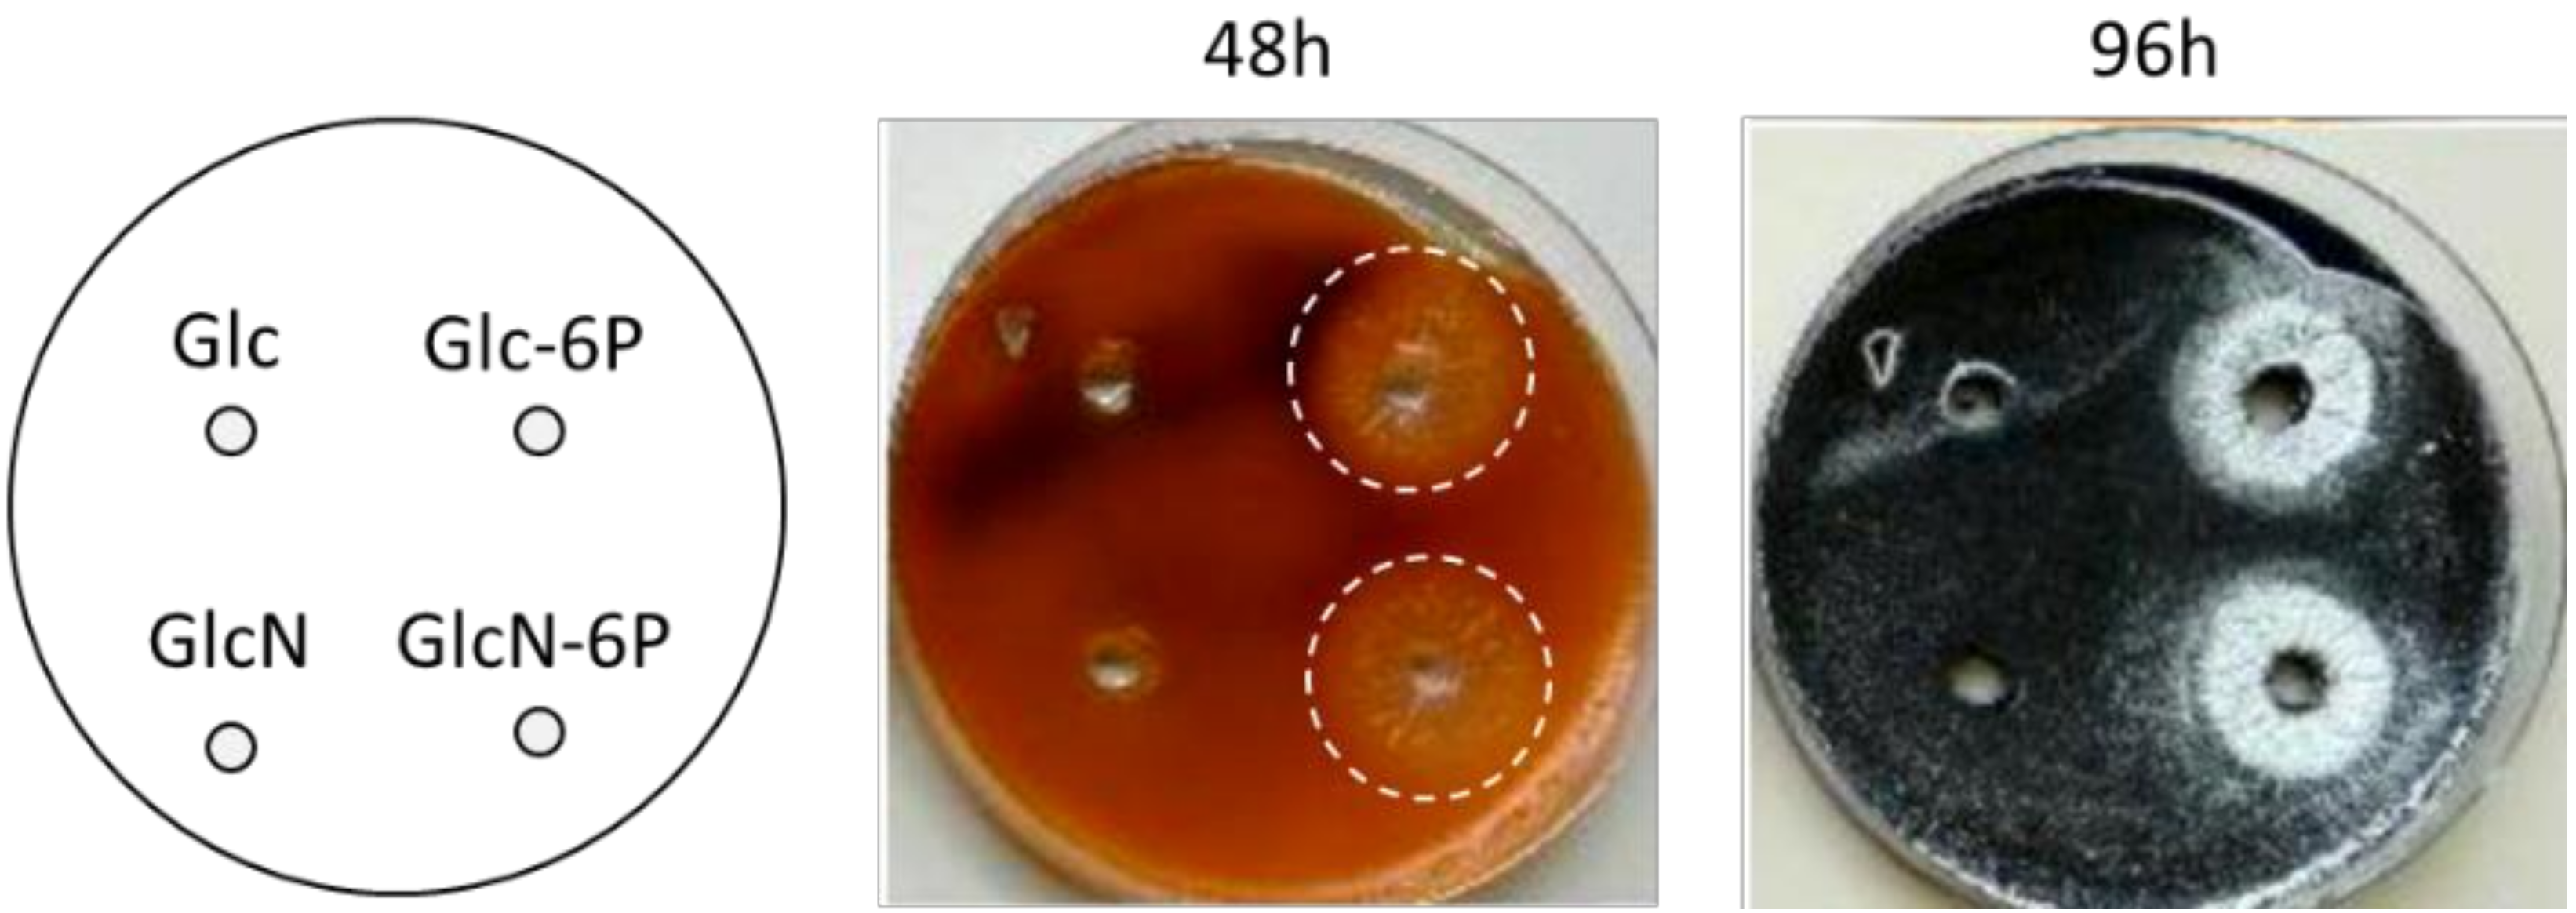
Antibiotics 09 00847 g003 Antibiotics 09 00847 g003

Prodiginines Postpone the Onset of Sporulation in Streptomyces coelicolor
Abstract
1. Introduction
2. Results
2.1. Inhibition of PdGs Synthesis Causes Precocious Onset of S. coelicolor Morphological Differentiation
2.2. Inhibition of Prodiginine Synthesis Accelerates Transcription of the Late Developmental Genes
2.3. Survival of S. coelicolor to Prodiginine Production
3. Discussion
4. Materials and Methods
4.1. Strains and Culture Conditions
4.2. Antibiotic Production
4.3. Transcriptional Analysis
4.4. Scanning Electron Microscopy
4.5. In Situ Visualization by Confocal Fluorescence Microscopy
5. Conclusions
Author Contributions
Funding
Acknowledgments
Conflicts of Interest
References
- Hopwood, D.A. Streptomyces in Nature and Medicine: The Antibiotic Makers; Oxford University Press: Oxford, UK; New York, NY, USA, 2007; ISBN 978-0-19-515066-7. [Google Scholar]
- De Lima Procópio, R.E.; da Silva, I.R.; Martins, M.K.; de Azevedo, J.L.; de Araújo, J.M. Antibiotics produced by Streptomyces. Br. J. Infect. Dis. 2012, 16, 466–471. [Google Scholar] [CrossRef] [PubMed]
- Barka, E.A.; Vatsa, P.; Sanchez, L.; Gaveau-Vaillant, N.; Jacquard, C.; Klenk, H.-P.; Clément, C.; Ouhdouch, Y.; van Wezel, G.P. Taxonomy, Physiology, and Natural Products of Actinobacteria. Microbiol. Mol. Biol. Rev. 2016, 80, 1–43. [Google Scholar] [CrossRef] [PubMed]
- Chater, K.F.; Losick, R. Mycelial Life Style of Streptomyces Coelicolor A3(2) and Itrs Relatives—ScienceOpen. Available online: https://www.scienceopen.com/document?vid=6454b2cc-fcaa-425d-ad02-32c6e84e0f72 (accessed on 24 November 2020).
- Shapiro, J.A.; Dworkin, M. Bacteria As Multicellular Organisms; Multicellular and Interactive Behavior of Bacteria. In Nature, Industry and The Laboratory; Oxford University Press: Oxford, UK; New York, NY, USA, 1997; ISBN 978-0-19-509159-5. [Google Scholar]
- Claessen, D.; Rozen, D.E.; Kuipers, O.P.; Søgaard-Andersen, L.; Van Wezel, G.P. Bacterial solutions to multicellularity: A tale of biofilms, filaments and fruiting bodies. Nat. Rev. Microbiol. 2014, 12, 115–124. [Google Scholar] [CrossRef] [PubMed]
- Bibb, M.J. Regulation of secondary metabolism in streptomycetes. Curr. Opin. Microbiol. 2005, 8, 208–215. [Google Scholar] [CrossRef]
- Martín, J.F.; Sola-Landa, A.; Santos-Beneit, F.; Fernández-Martínez, L.T.; Prieto, C.; Rodríguez-García, A. Cross-talk of global nutritional regulators in the control of primary and secondary metabolism in Streptomyces. Microb. Biotechnol. 2011, 4, 165–174. [Google Scholar] [CrossRef]
- Van Der Heul, H.U.; Bilyk, B.L.; McDowall, K.J.; Seipke, R.F.; Van Wezel, G.P. Regulation of antibiotic production in Actinobacteria: New perspectives from the post-genomic era. Nat. Prod. Rep. 2018, 35, 575–604. [Google Scholar] [CrossRef]
- Urem, M.; Świątek-Połatyńska, M.A.; Rigali, S.; van Wezel, G.P. Intertwining nutrient-sensory networks and the control of antibiotic production in Streptomyces. Mol. Microbiol. 2016, 102, 183–195. [Google Scholar] [CrossRef]
- Abrudan, M.I.; Brown, S.; Rozen, D.E. Killing as means of promoting biodiversity. Biochem. Soc. Trans. 2012, 40, 1512–1516. [Google Scholar] [CrossRef]
- Abrudan, M.I.; Smakman, F.; Grimbergen, A.J.; Westhoff, S.; Miller, E.L.; Van Wezel, G.P.; Rozen, D.E. Socially mediated induction and suppression of antibiosis during bacterial coexistence. Proc. Natl. Acad. Sci. USA 2015, 112, 11054–11059. [Google Scholar] [CrossRef]
- Tenconi, E.; Traxler, M.F.; Hoebreck, C.; van Wezel, G.P.; Rigali, S. Production of prodiginines is part of a programmed cell death process in Streptomyces coelicolor. Front. Microbiol. 2018, 9, 1–12. [Google Scholar] [CrossRef]
- Davies, J.; Spiegelman, G.B.; Yim, G. The world of subinhibitory antibiotic concentrations. Curr. Opin. Microbiol. 2006, 9, 445–453. [Google Scholar] [CrossRef] [PubMed]
- Dietrich, L.E.P.; Teal, T.K.; Price-Whelan, A.; Newman, D.K. Redox-active antibiotics control gene expression and community behavior in divergent bacteria. Science 2008, 321, 1203–1206. [Google Scholar] [CrossRef] [PubMed]
- Linares, J.F.; Gustafsson, I.; Baquero, F.; Martinez, J.L. Antibiotics as intermicrobiol signaling agents instead of weapons. Proc. Natl. Acad. Sci. USA 2006, 103, 19484–19489. [Google Scholar] [CrossRef] [PubMed]
- Lugtenberg, B.; Rozen, D.E.; Kamilova, F. Wars between microbes on roots and fruits. F1000Research 2017, 6, 343. [Google Scholar] [CrossRef] [PubMed]
- Romero, D.; Traxler, M.F.; López, D.; Kolter, R. Antibiotics as signal molecules. Chem. Rev. 2011, 111, 5492–5505. [Google Scholar] [CrossRef] [PubMed]
- Traxler, M.F.; Seyedsayamdost, M.R.; Clardy, J.; Kolter, R. Interspecies modulation of bacterial development through iron competition and siderophore piracy. Mol. Microbiol. 2012, 86, 628–644. [Google Scholar] [CrossRef]
- Virolle, M.J. A challenging view: Antibiotics play a role in the regulation of the energetic metabolism of the producing bacteria. Antibiotics 2020, 9, 83. [Google Scholar] [CrossRef]
- Yim, G.; Wang, H.H.; Davies, J. Antibiotics as signalling molecules. Philos. Trans. R. Soc. B Biol. Sci. 2007, 362, 1195–1200. [Google Scholar] [CrossRef]
- van der Meij, A.; Worsley, S.F.; Hutchings, M.I.; van Wezel, G.P. Chemical ecology of antibiotic production by actinomycetes. FEMS Microbiol. Rev. 2017, 41, 392–416. [Google Scholar] [CrossRef]
- Esnault, C.; Dulermo, T.; Smirnov, A.; Askora, A.; David, M.; Deniset-Besseau, A.; Holland, I.B.; Virolle, M.J. Strong antibiotic production is correlated with highly active oxidative metabolism in Streptomyces coelicolor M145. Sci. Rep. 2017, 7. [Google Scholar] [CrossRef]
- Davies, J.; Ryan, K.S. Introducing the parvome: Bioactive compounds in the microbial world. ACS Chem. Biol. 2012, 7, 252–259. [Google Scholar] [CrossRef] [PubMed]
- Davies, J. How to discover new antibiotics: Harvesting the parvome. Curr. Opin. Chem. Biol. 2011, 15, 5–10. [Google Scholar] [CrossRef]
- Kronheim, S.; Daniel-Ivad, M.; Duan, Z.; Hwang, S.; Wong, A.I.; Mantel, I.; Nodwell, J.R.; Maxwell, K.L. A chemical defence against phage infection. Nature 2018, 564, 283–286. [Google Scholar] [CrossRef]
- Tenconi, E.; Rigali, S. Self-resistance mechanisms to DNA-damaging antitumor antibiotics in actinobacteria. Curr. Opin. Microbiol. 2018, 45, 100–108. [Google Scholar] [CrossRef] [PubMed]
- Suryawanshi, R.K.; Patil, C.D.; Koli, S.H.; Hallsworth, J.E.; Patil, S.V. Antimicrobial activity of prodigiosin is attributable to plasma-membrane damage. Nat. Prod. Res. 2017, 31, 572–577. [Google Scholar] [CrossRef] [PubMed]
- Montaner, B.; Castillo-Ávila, W.; Martinell, M.; Öllinger, R.; Aymami, J.; Giralt, E.; Pérez-Tomás, R. DNA interaction and dual topoisomerase I and II inhibition properties of the anti-tumor drug prodigiosin. Toxicol. Sci. 2005, 85, 870–879. [Google Scholar] [CrossRef]
- You, Z.; Zhang, S.; Liu, X.; Zhang, J.; Wang, Y.; Peng, Y.; Wu, W. Insights into the anti-infective properties of prodiginines. Appl. Microbiol. Biotechnol. 2019, 103, 2873–2887. [Google Scholar] [CrossRef]
- Mo, S.J.; Sydor, P.K.; Corre, C.; Alhamadsheh, M.M.; Stanley, A.E.; Haynes, S.W.W.; Song, L.; Reynolds, K.A.; Challis, G.L. Elucidation of the Streptomyces coelicolor Pathway to 2-Undecylpyrrole, a Key Intermediate in Undecylprodiginine and Streptorubin B Biosynthesis. Chem. Biol. 2008, 15, 137–148. [Google Scholar] [CrossRef]
- Claverys, J.P.; Håvarstein, L.S. Cannibalism and fratricide: Mechanisms and raisons d’être. Nat. Rev. Microbiol. 2007, 5, 219–229. [Google Scholar] [CrossRef]
- Manteca, A.; Mäder, U.; Connolly, B.A.; Sanchez, J. A proteomic analysis of Streptomyces coelicolor programmed cell death. Proteomics 2006, 6, 6008–6022. [Google Scholar] [CrossRef]
- Yagüe, P.; López-García, M.T.; Rioseras, B.; Sánchez, J.; Manteca, Á. Pre-sporulation stages of Streptomyces differentiation: State-of-the-art and future perspectives. FEMS Microbiol. Lett. 2013, 342, 79–88. [Google Scholar] [CrossRef] [PubMed]
- Nariya, H.; Inouye, M. MazF, an mRNA Interferase, Mediates Programmed Cell Death during Multicellular Myxococcus Development. Cell 2008, 132, 55–66. [Google Scholar] [CrossRef] [PubMed]
- Jiang, Q.; Qin, S.; Wu, Q. yu Genome-wide comparative analysis of metacaspases in unicellular and filamentous cyanobacteria. BMC Genomics 2010, 11, 198. [Google Scholar] [CrossRef] [PubMed]
- Filippova, S.N.; Vinogradova, K.A. Programmed cell death as one of the stages of streptomycete differentiation. Microbiology 2017, 86, 439–454. [Google Scholar] [CrossRef]
- Yang, K.; Chen, Q.; Zhang, D.; Zhang, H.; Lei, X.; Chen, Z.; Li, Y.; Hong, Y.; Ma, X.; Zheng, W.; et al. The algicidal mechanism of prodigiosin from Hahella sp. KA22 against Microcystis aeruginosa. Sci. Rep. 2017, 7, 7750. [Google Scholar] [CrossRef]
- Zhang, S.; Zheng, W.; Wang, H. Physiological response and morphological changes of Heterosigma akashiwo to an algicidal compound prodigiosin. J. Hazard. Mater. 2020, 385, 121530. [Google Scholar] [CrossRef]
- Bibb, M.J.; Molle, V.; Buttner, M.J. σ(BldN), an extracytoplasmic function RNA polymerase sigma factor required for aerial mycelium formation in Streptomyces coelicolor A3(2). J. Bacteriol. 2000, 182, 4606–4616. [Google Scholar] [CrossRef]
- Claessen, D.; Stokroos, L.; Deelstra, H.J.; Penninga, N.A.; Bormann, C.; Salas, J.A.; Dijkhuizen, L.; Wösten, H.A.B. The formation of the rodlet layer of streptomycetes is the result of the interplay between rodlins and chaplins. Mol. Microbiol. 2004, 53, 433–443. [Google Scholar] [CrossRef]
- Claessen, D.; Wösten, H.A.B.; Van Keulen, G.; Faber, O.G.; Alves, A.M.C.R.; Meijer, W.G.; Dijkhuizen, L. Two novel homologous proteins of Streptomyces coelicolor and Streptomyces lividans are involved in the formation of the rodlet layer and mediate attachment to a hydrophobic surface. Mol. Microbiol. 2002, 44, 1483–1492. [Google Scholar] [CrossRef]
- Elliot, M.A.; Karoonuthaisiri, N.; Huang, J.; Bibb, M.J.; Cohen, S.N.; Kao, C.M.; Buttner, M.J. The chaplins: A family of hydrophobic cell-surface proteins involved in aerial mycelium formation in Streptomyces coelicolor. Genes Dev. 2003, 17, 1727–1740. [Google Scholar] [CrossRef]
- Capstick, D.S.; Willey, J.M.; Buttner, M.J.; Elliot, M.A. SapB and the chaplins: Connections between morphogenetic proteins in Streptomyces coelicolor. Mol. Microbiol. 2007, 64, 602–613. [Google Scholar] [CrossRef] [PubMed]
- Bibb, M.J.; Domonkos, Á.; Chandra, G.; Buttner, M.J. Expression of the chaplin and rodlin hydrophobic sheath proteins in Streptomyces venezuelae is controlled by σ BldN and a cognate anti-sigma factor, RsbN. Mol. Microbiol. 2012, 84, 1033–1049. [Google Scholar] [CrossRef] [PubMed]
- Kodani, S.; Hudson, M.E.; Durrant, M.C.; Buttner, M.J.; Nodwell, J.R.; Willey, J.M. The SapB morphogen is a lantibiotic-like peptide derived from the product of the developmental gene ramS in Streptomyces coelicolor. Proc. Natl. Acad. Sci. USA 2004, 101, 11448–11453. [Google Scholar] [CrossRef] [PubMed]
- Kelemen, G.H.; Brian, P.; Flärdh, K.; Chamberlin, L.; Chater, K.F.; Buttner, M.J. Developmental regulation of transcription of whiE, a locus specifying the polyketide spore pigment in Streptomyces coelicolor A3(2). J. Bacteriol. 1998, 180, 2515–2521. [Google Scholar] [CrossRef]
- Lawlor, E.J.; Baylis, H.A.; Chater, K.F. Pleiotropic morphological and antibiotic deficiencies result from mutations in a gene encoding a tRNA-like product in Streptomyces coelicolor A3(2). Genes Dev. 1987, 1, 1305–1310. [Google Scholar] [CrossRef]
- Ryding, N.J.; Kelemen, G.H.; Whatling, C.A.; Flärdh, K.; Buttner, M.J.; Chater, K.F. A developmentally regulated gene encoding a repressor-like protein is essential for sporulation in Streptomyces coelicolor A3(2). Mol. Microbiol. 1998, 29, 343–357. [Google Scholar] [CrossRef]
- Tenconi, E.; Jourdan, S.; Motte, P.; Virolle, M.J.; Rigali, S. Extracellular sugar phosphates are assimilated by Streptomyces in a PhoP-dependent manner. Antonie Van Leeuwenhoek 2012, 102, 425–433. [Google Scholar] [CrossRef]
- Huang, J.; Lih, C.J.; Pan, K.H.; Cohen, S.N. Global analysis of growth phase responsive gene expression and regulation of antibiotic biosynthetic pathways in Streptomyces coelicolor using DNA microarrays. Genes Dev. 2001, 15, 3183–3192. [Google Scholar] [CrossRef]
- Li, Y.; Chen, P.; Chen, S.; Wu, D.; Zheng, J. A pair of two-component regulatory genes ecrA1/A2 in S. coelicolor. J. Zhejiang Univ. Sci 2004, 5, 173–179. [Google Scholar] [CrossRef]
- Wang, C.; Ge, H.; Dong, H.; Zhu, C.; Li, Y.; Zheng, J.; Cen, P. A novel pair of two-component signal transduction system ecrE 1/ecrE2 regulating antibiotic biosynthesis in Streptomyces coelicolor. Biologia. 2007, 62, 511–516. [Google Scholar] [CrossRef]
- McAuley, S.; Huynh, A.; Howells, A.; Walpole, C.; Maxwell, A.; Nodwell, J.R. Discovery of a Novel DNA Gyrase-Targeting Antibiotic through the Chemical Perturbation of Streptomyces venezuelae Sporulation. Cell Chem. Biol. 2019, 26, 1274–1282. [Google Scholar] [CrossRef] [PubMed]
- Sun, J.; Kelemen, G.H.; Fernández-Abalos, J.M.; Bibb, M.J. Green fluorescent protein as a reporter for spatial and temporal gene expression in Streptomyces coelicolor A3(2). Microbiology 1999, 145, 2221–2227. [Google Scholar] [CrossRef] [PubMed]
- Zhou, L.H.; Li, Y.Q.; Li, Y.Q.; Wu, D. Spatio-temporal expression of the pathway-specific regulatory gene redD in S. coelicolor. J. Zhejiang Univ. Sci. 2005, 6, 464–469. [Google Scholar] [CrossRef] [PubMed]
- Floriano, B.; Bibb, M. afsR is a pleiotropic but conditionally required regulatory gene for antibiotic production in Streptomyces coelicolor A3(2). Mol. Microbiol. 1996, 21, 385–396. [Google Scholar] [CrossRef] [PubMed]
- Van Wezel, G.P.; White, J.; Hoogvliet, G.; Bibb, M.J. Application of redD, the transcriptional activator gene of the undecylprodigiosin biosynthetic pathway, as a reporter for transcriptional activity in Streptomyces coelicolor A3(2) and Streptomyces lividans. J. Mol. Microbiol. Biotechnol. 2000, 2, 551–556. [Google Scholar] [PubMed]
- Kieser, T.; Bibb, M.J.; Buttner, M.J.; Chater, K.F.; Hopwood, D.A. Practical Streptomyces genetics. In Practical Streptomyces Genetics; John Innes Foundation: Norwich, UK, 2000. [Google Scholar]
- Tenconi, E.; Guichard, P.; Motte, P.; Matagne, A.; Rigali, S. Use of red autofluorescence for monitoring prodiginine biosynthesis. J. Microbiol. Methods 2013, 93, 138–143. [Google Scholar] [CrossRef] [PubMed]
- Bystrykh, L.V.; Fernández-Moreno, M.A.; Herrema, J.K.; Malpartida, F.; Hopwood, D.A.; Dijkhuizen, L. Production of actinorhodin-related “blue pigments” by Streptomyces coelicolor A3(2). J. Bacteriol. 1996, 178, 2238–2244. [Google Scholar] [CrossRef]
- Lambert, S.; Traxler, M.F.; Craig, M.; Maciejewska, M.; Ongena, M.; Van Wezel, G.P.; Kolter, R.; Rigali, S. Altered desferrioxamine-mediated iron utilization is a common trait of bald mutants of Streptomyces coelicolor. Metallomics 2014, 6, 1390–1399. [Google Scholar] [CrossRef]
- Maciejewska, M.; Adam, D.; Naômé, A.; Martinet, L.; Tenconi, E.; Calusinska, M.; Delfosse, P.; Hanikenne, M.; Baurain, D.; Compère, P.; et al. Assessment of the potential role of Streptomyces in cave moonmilk formation. Front. Microbiol. 2017, 8, 1–18. [Google Scholar] [CrossRef]

Publisher’s Note: MDPI stays neutral with regard to jurisdictional claims in published maps and institutional affiliations. |
© 2020 by the authors. Licensee MDPI, Basel, Switzerland. This article is an open access article distributed under the terms and conditions of the Creative Commons Attribution (CC BY) license (http://creativecommons.org/licenses/by/4.0/).
Share and Cite
Tenconi, E.; Traxler, M.; Tellatin, D.; van Wezel, G.P.; Rigali, S. Prodiginines Postpone the Onset of Sporulation in Streptomyces coelicolor. Antibiotics 2020, 9, 847. https://doi.org/10.3390/antibiotics9120847
Tenconi E, Traxler M, Tellatin D, van Wezel GP, Rigali S. Prodiginines Postpone the Onset of Sporulation in Streptomyces coelicolor. Antibiotics. 2020; 9(12):847. https://doi.org/10.3390/antibiotics9120847
Chicago/Turabian StyleTenconi, Elodie, Matthew Traxler, Déborah Tellatin, Gilles P. van Wezel, and Sébastien Rigali. 2020. "Prodiginines Postpone the Onset of Sporulation in Streptomyces coelicolor" Antibiotics 9, no. 12: 847. https://doi.org/10.3390/antibiotics9120847
APA StyleTenconi, E., Traxler, M., Tellatin, D., van Wezel, G. P., & Rigali, S. (2020). Prodiginines Postpone the Onset of Sporulation in Streptomyces coelicolor. Antibiotics, 9(12), 847. https://doi.org/10.3390/antibiotics9120847

